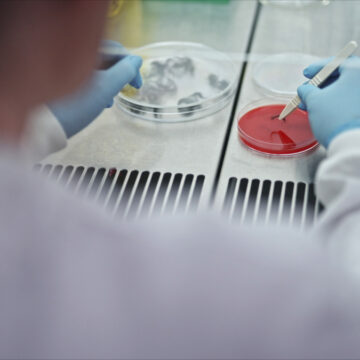

L’appuntamento con Dyson per l’evento Pet Science è in piazza Gae Aulenti a Milano, ma solo fino a domenica 3 luglio, per provare di persona, dal vivo e in funzione, la potenza e la praticità d’uso dei rinnovati aspirapolvere senza filo Dyson, incluse le nuove spazzole con tecnologia anti-groviglio, un accessorio per la toelettatura degli animali, la nuova spazzola delicata anti-graffio e una bocchetta a lancia per spazi ristretti
Con approccio scientifico i visitatori sono guidati attraverso un viaggio all’interno della polvere e delle sue componenti, in particolare quelle derivanti dalla presenza in casa dei nostri amici a quattro zampe, come polline, virus, feci degli acari della polvere, batteri e residui di pelle.
Grazie al supporto di esperti e ingegneri Dyson, i nuovi aspirapolvere senza filo Dyson sono presentati e messi alla prova, con un approfondimento sulla tecnologia anti-groviglio, progettata per affrontare qualsiasi tipologia di peli e capelli, sia quelli di cani e gatti, sia quelli umani.
Per conoscere più da vicino il mondo degli animali domestici, il palinsesto dell’evento prevede la partecipazione di esperti di settore, dall’educatore cinofilo al veterinario, che forniscono consigli utili su come prendersi cura dei propri amici a quattro zampe. Grazie alla presenza di toelettatori professionisti, i visitatori possono usufruire di una coccola speciale per i propri animali, mentre vedono in azione il nuovo accessorio Dyson per la loro toelettatura.
Dyson Pet Sciece, ulteriori informazioni
L’evento Dyson Pet Science si svolge in Piazza Gae Aulenti a Milano, con apertura al pubblico da giovedì 30 giugno dalle ore 15:30 alle ore 20 e da venerdì 1 luglio a domenica 3 luglio dalle ore 10 alle ore 20. È possibile usufruire di consulenze personalizzate e di un servizio speciale dedicato al proprio animale, previa prenotazione in loco. Per ragioni di sicurezza ci sono specifiche regole di accesso per gli animali domestici, che vengono comunicate in loco.
Per poter usufruire di una consulenza personalizzata e scegliere la tecnologia ideale per le proprie esigenze, è possibile visitare i Dyson Demo Store, situati nelle principali città italiane, o usufruire dei servizi dedicati sul sito web Dyson.
A fine maggio Dyson ha aperto i suoi laboratori per mostrare i prototipi dei robot elettrodomestici del futuro: la multinazionale cerca e assume brillanti ingegneri in svariati campi. Tra gli ultimi prodotti annunciati da Dyson, le cuffie Zone con audio Hi-Fi che purificano anche l’aria respirata dall’utente. Tutti gli articoli che parlano di Dyson sono disponibili a partire da questa pagina di macitynet.